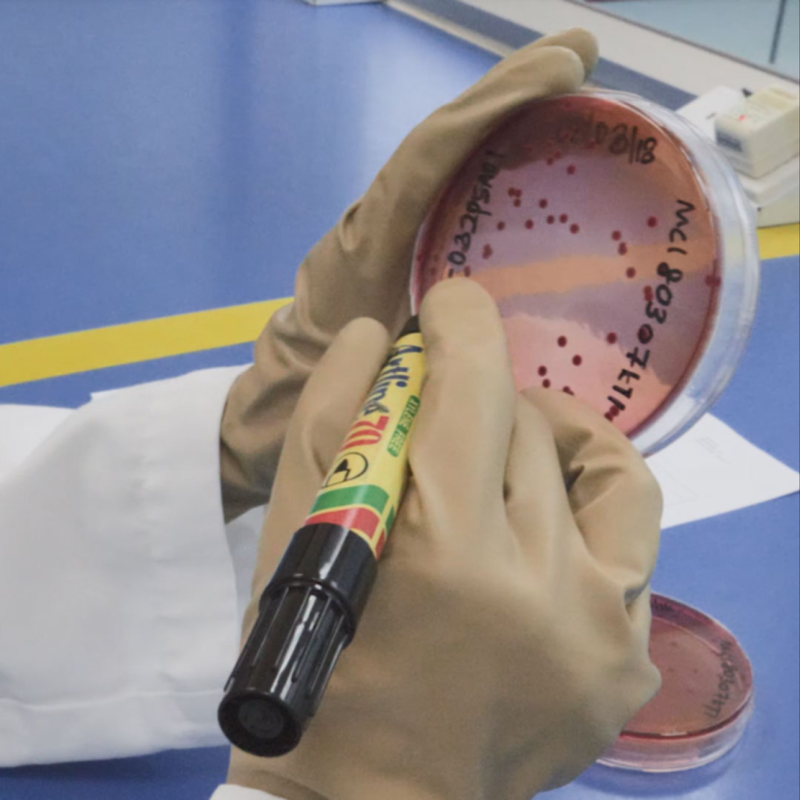

Wenn das Behandlungsergebnis in Ihren Händen liegt, brauchen Sie diese Handschuhe.
- Die innovativen Handschuhlösungen von Biogel® ermöglichen es Ihnen, Ihr gesamtes berufliches Können einzusetzen
- Gleichzeitig Ihre wertvollsten Werkzeuge zu schützen
- Unsere patentierte Technologie ist einzigartig
- Sie bietet höchsten Tragekomfort und maximal präzises Tastempfinden.
Die Vorteile von Biogel

Mit der optimalen Passform können Sie Ihr Bestes geben.
Hände gibt es in vielen Formen und Größen. Biogel® Handschuhe auch. Basierend auf Ihren anatomischen Messungen und Ihren beruflichen Bedürfnissen, bieten wir die für Sie am besten geeigneten Handschuhlösungen. Steigern Sie Ihre Genauigkeit und Komfort.
Jede Situation meistern. Beste Resultate erzielen.
Mit einem auserlesenen und individuellen Handschuh-Portfolio erzielen Sie bei jeder Operation die beste Leistung. Deswegen bieten wir ein zuverlässiges Lösungssystem für jegliche Situationen, die im OP vorkommen können. Das schützt Sie vor Überraschungen.
Ihre Hände müssen gesund bleiben.
Hände, die Leben retten, verdienen den besten Schutz. Nicht nur vor Verletzungen und Infektionen, sondern auch vor Hautreaktionen, Trockenheit und Ermüdung. Deshalb werden alle Biogel® Handschuhe durchgehend unter Berücksichtigung des allgemeinen Wohlbefindens Ihrer Hände entwickelt. Das bringt Ihnen dauerhafte Leistungsfähigkeit im OP.
Warum Biogel genau der richtige Partner für Sie ist?
-
- Eindeutigste Perforationserkennung im Markt
- Kontinuierliche Qualitätssicherung für bestmöglichen Schutz
- Sorgt für maximale Mitarbeiter- und Patientensicherheit
- Höchster Tragekomfort mit präzisem Tastempfinden
- Portfolio und übersichtliches Sortiment für optimale Lieferantenstraffung
-

-

-
Kosten senken, herausragende Qualität erhalten
Unser System bietet die eindeutigste Perforationserkennung im Markt. Dazu garantiert der Doppelhandschuh Sicherheit für medizinisches Personal und Patienten.
Denn selbst kleinste Risse und Perforationen werden im OP-Handschuh schnell erkannt, wodurch das Infektionsrisiko nachweislich reduziert wird. Das spart Zeit, erhöht die Effizienz im OP und senkt die damit verbundenen Kosten.
Denn weniger Infektionen bedeuten weniger zusätzliche Behandlungskosten, kürzere Krankenhausaufenthalte, sowie besserer Schutz des Personals.
-
Große Auswahl für eine effiziente Versorgung
Durch unser großes Sortiment an qualitativ hochwertigen Handschuhen kann das OP-Team auf jede Herausforderung flexibel reagieren.
Lieferantenstraffung ist aufgrund unserer umfangreichen Produktpalette (Latex, Latexfrei, Einzel- und Doppelsysteme sowie verschiedene Materialien) problemlos möglich. Denn Biogel bietet für jede Hand eine individuelle Lösung.
-

-

-
Mit Mölnlycke auf der sicheren Seite
Mölnlycke wurde im EcoVadis-Nachhaltigkeitsrating mit der Platinmedaille ausgezeichnet und gehört damit zu den besten 1 % aller bewerteten Unternehmen weltweit.
Mit dieser Bewertung werden die Stärken von Mölnlycke in den Bereichen Umweltmanagement, Arbeits- und Menschenrechte, ethische Unternehmensführung und nachhaltige Lieferkettenpartnerschaften anerkannt.
Bei Biogel® steht die Sicherheit Ihrer Mitarbeiter und Patienten an erster Stelle.
Deshalb durchläuft jeder einzelne OP-Handschuh umfangreiche und strenge Qualitätsprüfungen, bevor er die Fabrik verlässt. Unser Anspruch an Qualität setzt branchenweit neue Maßstäbe – damit Sie stets das Beste erwarten können.
Präzise Qualitätskontrollen in jeder Produktionsphase
Unsere Handschuhe werden unter kontrollierten Bedingungen geprüft – in klimatisierten Räumen mit exakt regulierter Temperatur und Luftfeuchtigkeit. Diese Sorgfalt gewährleistet, dass jeder Handschuh die höchsten Standards erfüllt.
-

-
Stichprobenbasierte Qualitätsprüfung jeder Charge:
Physikalische Tests: Prüfung auf Reißfestigkeit und Materialeigenschaften.
Wasserleckagetests: Aufspüren kleinster Perforationen Verpackungs- und Kennzeichnungsprüfung zur Sicherstellung der Sterilität Sterilisationsbestätigung für höchste Produktsicherheit.
-
100 % Prüfung mit QMAX-Technologie:
Jeder Biogel® OP-Handschuh wird einzeln aufgeblasen und auf Löcher überprüft. Diese einzigartige Methode bietet maximale Sicherheit und minimiert das Risiko von Defekten.
-

-
-
Endotoxintests
Unsere Handschuhe sind die einzigen mit einem Endotoxin-Level von < 20 EU/Paar – weit unter dem üblichen Standard. Endotoxine können postoperative Komplikationen auslösen. Unsere wiederholten Tests gewährleisten eine zuverlässige Sicherheit für Ihre Patienten.
-
100 % puderfreie Produktion
Seit über 40 Jahren. Puder kann in Wunden postoperative Komplikationen verursachen – nicht mit Biogel®.
-

-

-
AQL von 0,4
Deutlich unter dem branchenüblichen Standard von 0,65. Dies garantiert, dass unsere Handschuhe frei von Löchern und Mikroperforationen sind und jedes Paar höchsten Ansprüchen genügt.
Feedback aus erster Hand
Hier möchten wir Ihnen nicht nur unser Versprechen geben, sondern auch die Erfahrungen unserer zufriedenen Kunden mit Ihnen teilen.
-
„Jeder Mitarbeiter und auch Chirurg kann frei wählen, welches System / welchen Handschuh er verwenden möchte. Wir empfehlen natürlich, Seitens der OP-Pflege, die Indikatorhandschuhe. Wenn wir adäquate Handschuhe im Arbeitsalltag zur Verfügung haben, können wir uns selbst optimal schützen und auch den Patienten vor den Keimen, die auf ihn einwirken schützen. An unseren Handschuhen schätzen wir die gleichbleibende Qualität, die optimale Passform und die Variabilität der Produkte.”
Bernhard Schnötzinger, OP-Leitung, Landeskrankenhaus Salzburg.
-

-

-
„Prozesse und Arbeitsschritte müssen verkürzt werden – Qualitätsprodukte sind daher für mich als Einkäufer wichtig - die Wirtschaftlichkeit bekommt dann für mich eine ganz andere Bedeutung. Pro Mitarbeiter würden bei einer Nadelstichverletzung täglich rund 710 Euro pro Tag anfallen (bezogen auf Lohnfortzahlungen etc.).”
Michael Bremshey, Stv. Leiter ZB Wirtschaft und Versorgung, Leitung Strategischer Einkauf bei der St. Paulus Gesellschaft.
-
„Ich habe eine Latex-Allergie. Da mir Sicherheit wichtig ist, benutze ich spezielle latexfreie OP-Handschuhe. Die Hände sind meine Werkzeuge, also meine Instrumente - meine Existenz“
Dr. med. Yasser Abdalla, Direktor der Klinik für Neurochirurgie am Krankenhaus Nordwest in Sande.
-

-

-
„Ob als Pfleger oder Arzt, sind die Hände das wichtigste Werkzeug und haben eine ganz hohe Bedeutung. Der Handschuh ist der Begleiter des Pflegers und des Arztes“
Dr. med. Roland Frank, Facharzt für Unfallchirurgie und Sporttraumatologie, Arzt für Arbeits- und Organisationsmedizin und Hygienearzt.

Wir sind für Sie da
Individuelle Beratung. Passgenauer Lösungen.
Unsere Spezialist:innen unterstützen Sie bei allen Fragen rund um Materialauswahl, Passform und Eigenschaften. Abgestimmt auf die Anforderungen Ihres medizinischen Fachpersonals.
Gemeinsam definieren wir die optimale Lösung für Ihren OP-Alltag.
Dabei beraten wir Sie nicht nur zur Produktauswahl, sondern auch zur Infektionsprävention, bewährten Praktiken und zur richtigen Anwendung von chirurgischen Handschuhen.
Die Handhabung von Biogel® Handschuhen unterscheidet sich nicht von anderen Marken. Die Gewöhnung dauert in der Regel maximal ein bis zwei Tage.
-

-
Engagierter Kundensupport
Unser engagierter Kundenservice ist immer für Sie da, um Ihre Anliegen schnellstmöglich zu bearbeiten und Ihnen eine exzellente Unterstützung zu bieten.
-
Kundenzufriedenheit im Mittelpunkt und offener Austausch
Ihre Zufriedenheit steht für uns an erster Stelle. Wir schätzen Ihr Feedback und setzen es aktiv ein, um unsere Produkte und Services kontinuierlich zu verbessern.
-

-

-
Maßgeschneiderte Optionen für Sie
Wir bieten individuelle Angebote, die auf Ihre speziellen Bedürfnisse zugeschnitten sind, um sicherzustellen, dass Sie die bestmögliche Lösung erhalten.
Wichtige Fragen und ihre Antworten
-
Was macht Biogel Handschuhe besonders?
Biogel Handschuhe zeichnen sich durch eine sehr niedrige Perforationsrate (AQL von 0,65) aus, was sie besonders sicher macht. Sie bieten außerdem ein exzellentes Tastempfinden und hohen Tragekomfort – auch bei langen Eingriffen.
-
Gibt es latexfreie Varianten?
Ja, Biogel bietet sowohl Latex- als auch latexfreie (Polyisopren-)Handschuhe an, um Allergien vorzubeugen.
-
Was ist das Biogel Indikatorsystem?
Das ist ein Doppelhandschuhsystem mit einer visuellen Perforationsanzeige. Es zeigt sofort an, wenn der äußere Handschuh beschädigt ist – für mehr Sicherheit im OP.
-
Inwieweit ist das Biogel Indicator® System nachhaltig?
Doppelt verpackte Indikatorensysteme bedeuten weniger Abfall, sind besser für die Umwelt und leichter durchsetzbar für ein DG-Protokoll.
-
Wie ist die Passform der Handschuhe?
Biogel Handschuhe sind anatomisch geformt und in vielen Größen erhältlich. Sie bieten eine angenehme Passform und reduzieren die Ermüdung der Hände.
-
Wie wird die Qualität sichergestellt?
Jeder Handschuh durchläuft strenge Qualitätskontrollen, darunter Drucklufttests und visuelle Inspektionen. Das Ziel ist eine möglichst geringe Fehlerquote.
-
Wie unterscheiden sich die Modelle (z. B. PI Micro, UltraTouch)?
Die Modelle unterscheiden sich in Wandstärke, Material (Latex vs. Polyisopren), Griffigkeit und Einsatzbereich. Der Biogel PI Micro z. B. ist besonders dünn für maximale Sensibilität.
-
Sie haben noch weitere Fragen?